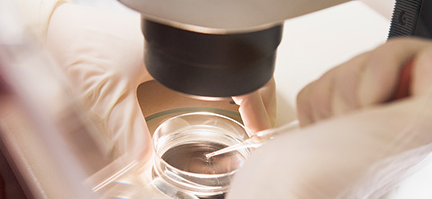

난소암 초기증상 5가지, 복부팽만과 소화불량이 신호일 수 있습니다

안녕하세요, 자유소유입니다 😊
여성이라면 한 번쯤은 들어봤을 난소암.
하지만 대부분의 여성들이 난소암 초기증상을 알아채지 못한 채, 병이 상당히 진행된 뒤에야 진단을 받는 경우가 많습니다.
그 이유는 초기에는 특별한 통증 없이 복부팽만, 소화불량, 배변 습관 변화 같은 흔한 증상으로 나타나기 때문인데요.
오늘은 여러분의 건강을 지키기 위해 꼭 알아야 할, 난소암 초기증상 5가지를 정리해드릴게요.





1. 복부팽만 – 계속 더부룩하다면 의심해보세요
많은 여성들이 난소암 증상 복부팽만을 단순한 소화불량으로 오해합니다.
하지만 아무리 먹는 걸 조심해도 복부가 부은 느낌이 계속되거나,
바지 단추가 갑자기 안 잠길 정도로 배가 나오는 느낌이 든다면 난소에 생긴 종양이 복수를 유발하고 있을 수 있습니다.
특히, 생리주기와 관계없이 지속되는 복부팽만이라면 반드시 산부인과에서 진찰을 받아보시길 권해요.





2. 소화불량 및 식욕 저하 – 위장이 아니라 난소의 신호일 수 있어요
"요즘 왜 이렇게 속이 안 좋지?"
"밥을 먹으면 금방 배가 불러…"
이런 증상, 위장이 아니라 난소에서 보내는 경고일 수도 있습니다.
난소암은 위장과 인접한 위치에 있어 위장관을 압박하거나 영향을 줄 수 있기 때문에,
소화장애, 구토, 식욕 부진 등의 증상으로 나타날 수 있습니다.
특히 기존에 없던 위장 증상이 최근 1~2달 내에 생겼다면, 꼭 검진을 받아보세요.





3. 골반 통증 또는 하복부 통증 – 생리통이 아닌데 계속 아프다면?
난소는 골반 안에 위치해 있기 때문에, 난소에 문제가 생기면 골반 주변 통증이 발생할 수 있어요.
생리 기간도 아닌데 묵직하거나 날카로운 통증이 반복된다면, 단순한 여성질환이 아니라 난소에 생긴 종양 때문일 수도 있습니다.
또한 일부 여성들은 성관계 중 통증을 느끼기도 합니다.
이 역시 난소암 자가진단 시 중요한 체크포인트입니다.





4. 배뇨 습관 변화 – 소변을 자주 보거나, 보기 힘들어졌다면
난소가 커지면 방광을 눌러 배뇨 활동에 영향을 줄 수 있어요.
따라서 갑자기 소변을 자주 보게 되거나,
반대로 소변을 봐도 개운하지 않고 잔뇨감이 생긴다면 난소암 초기증상일 수 있습니다.
물론 단순한 방광염이나 생리전 증상일 수도 있지만,
일주일 이상 증상이 계속된다면 조기진단을 받는 것이 안전합니다.





5. 이유 없는 피로감 & 체중 감소 – 몸이 보내는 위기의 신호
평소보다 쉽게 피곤해지고, 잠을 많이 자도 개운하지 않은 날이 반복된다면?
그리고 특별한 다이어트를 하지 않았는데도 체중이 빠진다면?
이런 경우 난소암 조기진단을 위한 검사가 필요할 수 있습니다.
체내 종양이 커지면서 영양 흡수에 영향을 주고, 면역 반응을 유도하면서 전신 피로를 유발할 수 있거든요.

보너스: 난소암 예방 방법 – 이렇게 실천해보세요
- 정기적인 부인과 검진: 최소 1년에 한 번, 정기 검진을 통해 난소 상태 체크
- 피임약 복용 여부 상담: 장기간 피임약 복용은 난소암 위험을 낮춘다는 연구도 있어요
- 건강한 체중 유지: 과체중은 난소암 위험 인자 중 하나입니다
- 가족력 체크: 유전적 요인이 큰 암이므로, 가족 중 난소암/유방암 이력이 있다면 조기검진 필수
- 스트레스 줄이기 & 충분한 수면: 면역력은 어떤 암 예방에서도 가장 중요한 기본!





마무리 요약 ✍️
✔️ 난소암 초기증상은 복부팽만, 소화불량, 골반통, 배뇨 이상, 피로감 등으로 나타납니다
✔️ 평범해 보이는 증상이 한 달 이상 지속된다면 꼭 검진 받아야 해요
✔️ 난소암 자가진단 체크리스트를 생활 속에서 꾸준히 실천하세요
✔️ 조기진단이 생존율을 높입니다. 예방은 정기검진부터 시작입니다 😊
‘이렇게’ 했더니 2분 만에 꿀잠… 美연구진도 놀란 수면법 공개!
‘이렇게’ 했더니 2분 만에 꿀잠… 美연구진도 놀란 수면법 공개! 안녕하세요, 자유소유입니다 😊“잠이 안 와요...” 한밤중 뒤척이며 스마트폰만 들여다보신 적 있으시죠?그런데, 최근 미국
yousoyou.co.kr
노화를 최소 10년 늦춘다는 ‘이 습관’, 의사들이 먼저 실천하는 이유
노화를 최소 10년 늦춘다는 ‘이 습관’, 의사들이 먼저 실천하는 이유 – 수면, 식습관, 운동만 챙겨도 인생이 달라집니다안녕하세요, 자유소유입니다 😊"늙는 게 두렵다"는 말, 다들 한 번쯤
yousoyou.co.kr
“죽기 직전, 100명 중 97명이 똑같이 남긴 마지막 한마디”
“죽기 직전, 100명 중 97명이 똑같이 남긴 마지막 한마디” 안녕하세요, 자유소유입니다.오늘은 삶의 마지막 순간에 사람들이 남긴 '마지막 한마디'에 대해 이야기해보려 합니다. 사람은 떠나는
yousoyou.co.kr
“부동산으로 노후 망친 3가지 실수 – 절대 하면 안 되는 선택”
“부동산으로 노후 망친 3가지 실수 – 절대 하면 안 되는 선택” 안녕하세요, 자유소유입니다 😊오늘은 "부동산으로 노후 망친 3가지 실수 – 절대 하면 안 되는 선택"이라는 주제로 이야기해
yousoyou.co.kr
당신이 자녀에게 바치는 그 사랑, 혹시 독이 되고 있진 않나요?
당신이 자녀에게 바치는 그 사랑, 혹시 독이 되고 있진 않나요?안녕하세요, 자유소유입니다 😊오늘은 "당신이 자녀에게 바치는 그 사랑, 혹시 독이 되고 있진 않나요?"라는 주제로 이야기해보려
yousoyou.co.kr
7일 동안 당근 한 개씩만 먹었더니, 뱃살 실종! 속는셈치고 보세요
7일 동안 당근 한 개씩만 먹었더니, 뱃살 실종! 속는셈치고 보세요안녕하세요, 자유소유입니다 😊솔직히 말해서 ‘당근 한 개’로 뱃살이 빠진다고요? 처음엔 저도 반신반의했어요.그런데요…
yousoyou.co.kr
'건강한 아름다움 정보' 카테고리의 다른 글
| 임신 잘되는 법 총정리 – 배란일 계산부터 착상 유도 자세까지 (산부인과 전문의도 추천) (0) | 2025.05.16 |
|---|---|
| 대마종자유 효능 총정리 – 갱년기부터 피부 개선+탈모 예방까지 (1) | 2025.05.16 |
| 코골이 줄이는 5가지 방법+코골이 방지 기구 추천(후기 포함) (0) | 2025.05.16 |
| 스쿼트 100개 30일 도전 효과: 엉덩이·허벅지 라인 어떻게 달라졌을까? (0) | 2025.05.15 |
| 생리 안 하는 이유 총정리 – 생리불순 원인+무월경 대처법 안내 (0) | 2025.05.13 |